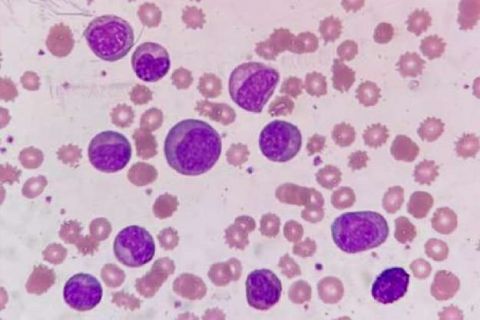

Produtores rurais poderão usar notas fiscais em papel remanescentes até 30 de abril

Desde a segunda-feira (05/01), a emissão de nota eletrônica passou a ser obrigatória para todos os produtores rurais em operações internas no Rio Grande do Sul. Atendendo a pedido de produtores, a Secretaria da Fazenda prorrogo, até 30 de abril o prazo para utilização do talão de produtor rural impresso remanescente, de modelo 4. A medida é válida para produtores rurais com receita bruta inferior a R$ 360 mil.
A ação visa garantir maior prazo de adequação às exigências que valem para todos os Estados a partir de norma definida no Conselho Nacional de Política Fazendária (Confaz). A Receita Estadual gaúcha, em diálogo com o setor, está publicando decreto estadual, que formaliza a prorrogação do uso da nota em papel, a contar de 5 de janeiro.
A partir de 1º de maio de 2026, fica vedada a emissão de Nota Fiscal de Produtor, modelo 4.
Entenda a mudança
O modelo 4 da Nota Fiscal, em papel, conhecido como talão do produtor, deixou de ser aceito desde o último dia 5. A mudança começou pela faixa produtores dos que têm maior faturamento e, aos poucos, foi expandida para pequenos produtores. A obrigatoriedade começou a valer em 2021 para os que tinham faturamento superior a R$ 4,8 milhões. Em janeiro de 2025, foram abrangidos também quem teve receita bruta de R$ 360 mil ou mais com a atividade rural, além de todas as operações interestaduais. Para o último grupo, foi flexibilizado o uso das notas em papel até 30 de abril.
AGILIDADE
A modernização da documentação fiscal no setor agropecuário é uma mudança nacional que torna o processo de emissão de notas mais ágil e seguro, reduzindo burocracias, minimizando falhas no preenchimento dos dados e evitando o risco da perda de documentos, além de antecipar a realidade após a Reforma Tributária, que deve extinguir completamente as notas em papel.
A Secretaria da Fazenda (Sefaz) oferece duas alternativas. O aplicativo Nota Fiscal Fácil (NFF), disponível para download gratuito pelo celular, é o mais indicado. Como muitos trabalhadores estão no campo, sem acesso à internet, o APP pode ser utilizado no modo offline. Desta forma, os usuários emitem a nota fiscal e, quando o aplicativo é conectado novamente a uma rede de internet, a nota é autorizada.
No próprio aplicativo, os produtores podem apontar problemas, sugerir recursos ou solicitar a inclusão de novos produtos para transação. Outra opção para a emissão de nota eletrônica é o Nota Fiscal Avulsa (NFA-e), também gratuito. O sistema é indicado para operações mais complexas, como, por exemplo, as de exportação.
Acesse o Manual de uso do aplicativo Nota Fiscal Fácil (NFF) acesse pelo https://atendimento.receita.rs.gov.br/upload/arquivos/202507/14093807-app-nff-manual-de-orientacao-do-produtor-rural-10-2024.pdf

.webp)

.jpg)


.jpg)

.jpg)







.jpg)


.jpg)












.jpg)
.jpg)
.jpg)





.jpg)

.jpg)




